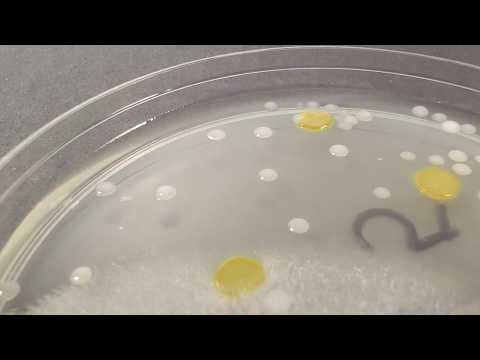

551,000 6.3%
3,210,000 2.78%
863,000 4.9%
10,600,000 5.29%
113,000 4.48%
180,000 2.19%
144,000 3.04%
135,000 6.35%
568,000 1.96%
299,000 5.27%
1,390,000 5.87%
2,480,000 4.31%
1,840,000 2.66%
155,000 7.7%
448,000 3.1%
72,300 1.29%
10,100,000 2.99%
567,000 4.18%
255,000 3.2%
10,500,000 3.02%
100,000 6.54%
426,000 5.59%
718,000 7.83%
194,000 5.28%
383,000 4.5%
509,000 6.83%